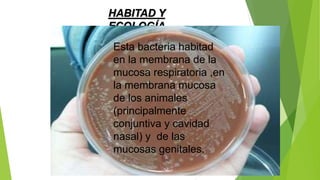
HABITAD Y
ECOLOGÍA
Esta bacteria habitad
en la membrana de la
mucosa respiratoria ,en
la membrana mucosa
de los animales
(principalmente
conjuntiva y cavidad
nasal) y de las
mucosas genitales.

Este documento describe el género bacteriano Haemophilus, incluyendo su taxonomía, hábitat, características celulares, de cultivo y bioquímicas. Discute varias especies de Haemophilus como H. agni, H. parasuis, H. somnus, H. paragallinarum, H. ducreyi e H. influenzae, y las enfermedades que causan en diferentes animales. También cubre el tratamiento de estas infecciones con antibióticos como ampicilina y cloramfenicol.